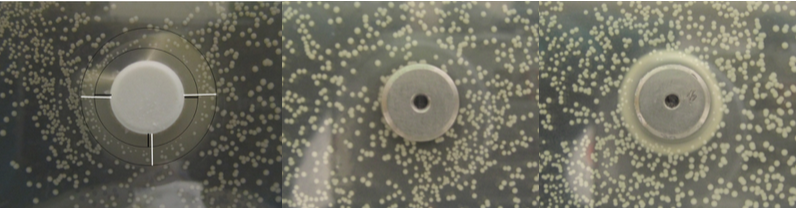

Elbacoss
Electrochemical bactericidal Ca(OH)2 implant coating as precursor for an osseoinductive HA layer
The rising number of periprosthetic infections has led to the development of various strategies for bactericidal implant coatings. In this project we investigated the approach of an inorganic calcium hydroxide Ca(OH)2 coating that expresses an initial antibacterial effect before it transforms into hydroxyapatite. Safety of this electrochemically deposited antimicrobial coating was shown preclinically, and the bactericidal effect was verified in-vitro.
Pyramid zementfreier Schaft
- P. Gruner, W. Moser, M. Wittwer, J. Rüegg, H. Holeczek, O. Braissant, K. Maniura, M. de Wild, An inorganic antimicrobial surface modification for orthopaedic implants, European Cells and Materials, 33, Suppl. 3, 55 (2017).
- N. Harrasser, M. de Wild, J. Gorkotte, A. Obermaier, S. Feihl, M. Straub, R. von Eisenhart-Rothe, H. Gollwitzer, J. Rüegg, W. Moser, Ph. Gruner, R. Burgkart, Evaluation of calcium dihydroxide- and silver-coated implants in the rat tibia, J Appl Biomater Funct Mater 14(4): e441-e448 (2016).
- N. Harrasser, J. Gorkotte, A. Obermeier, S. Feihl, M. Straub, J. Slotta-Huspenina, R. von Eisenhart-Rothe, W. Moser, Ph. Gruner, M. de Wild, H. Gollwitzer, R. Burgkart, A new model of implant-related osteomyelitis in the metaphysis of rat tibiae, BMC Musculoskeletal Disorders, 17:152 (2016).
- O. Braissant, D. Wirz, P. Gruner, R. Schumacher, U. Pieles, M. de Wild, P. Chavanne, S. Stevanovic, A. Bachmann, G. Bonkat, Growth at the interface: Testing antimicrobial properties of antimicrobial coating and porous surfaces, Swiss Society for Microbiology annual meeting in Fribourg, (2014).
- M. de Wild, Das Rennen, az Aargauer Zeitung, Basellandschaftliche Zeitung, Solothurner Zeitung, (Auflage 106'000), 31.5.2017.
- O. Braissant, P. Chavanne, M. de Wild, U. Pieles, S. Stevanovic, R. Schumacher, L. Straumann, D. Wirz, P. Gruner, A. Bachmann, G. Bonkat, A novel microcalorimetric assay for antibacterial activity of implant coatings: the cases of silver-doped hydroxyapatite and calcium hydroxide, JBMR B, 103(6):1161-7 (2015).
- Ph. Chavanne, O. Braissant, U. Pieles, Ph. Gruner, M. de Wild, R. Schumacher, Investigation on Bactericidal Effects of Silver Doped HA Structures. European Cells and Materials, 23, Suppl. 1, 31 (2012).